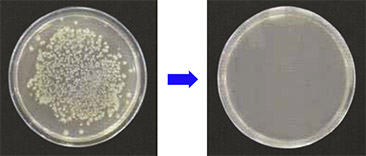

マスクやアルコールなど、一般的な対策は当たり前。既存の対策を実施したところで、売りにならない!

クラスター(店内大量感染)が発生したらその後は客足は遠のき、閉店必至!

実は、従業員が最も感染リスクに脅かされている!


何か新しい対策を始めないといけないとは思うけど探しても見つからない・わからない。











感染者・クラスターが発生したら1発アウト、営業停止。再開しても客足はすぐには戻らないでしょう。事実上の閉店・閉鎖。そうならないように事前の万全な対策が必要です。

既知のウイルス対策は、していることが当たり前の時代。対策不足の店は利用されなくなり、対策が万全の店にお客様の来店が集中する時代になります。

お客様だけでなく、従業員も危険にさらされています。店舗、会社内での感染者が発生した時の損害も計り知れません。より従業員の働きやすい環境が整います。

クローゼット

玄関

キッチン

トイレ

飲食店

病院

タクシー

エレベーター

